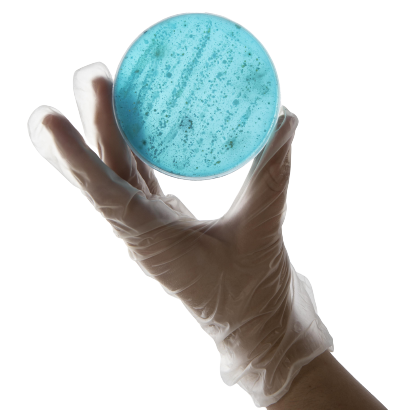

¡Qué bueno que ya estás aquí!
Es momento de potenciar tu perfil profesional.
Con TrainingLab adquirirás las habilidades técnicas que la industria demanda.



Certifícate con contenido de alta calidad académica.


Clases híbridas, online en vivo y presenciales en laboratorio, para que pongas en práctica los conocimientos adquiridos.